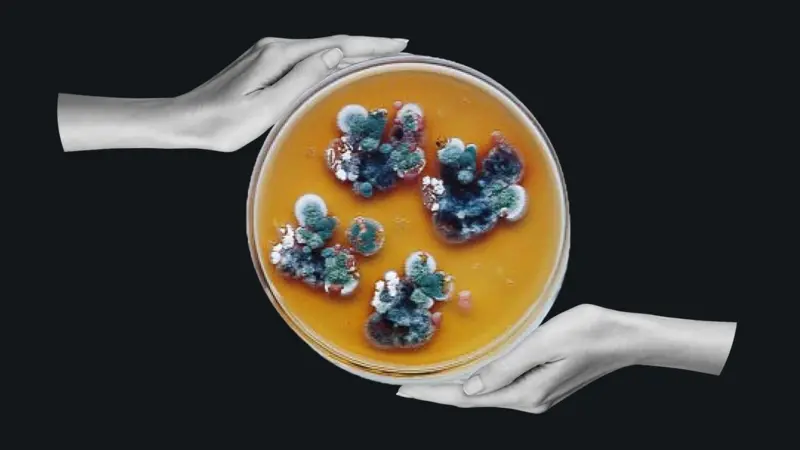
HeadlineImage

2025-12-16 04:00:08
La dominatriz que creó una empresa para enfrentar la "pornovenganza"

2025-12-13 14:00:04
Por qué hay donantes de esperma que acaban teniendo cientos de hijos
2025-12-02 04:00:04
El moho negro de Chernobyl que parece "alimentarse de radiación"